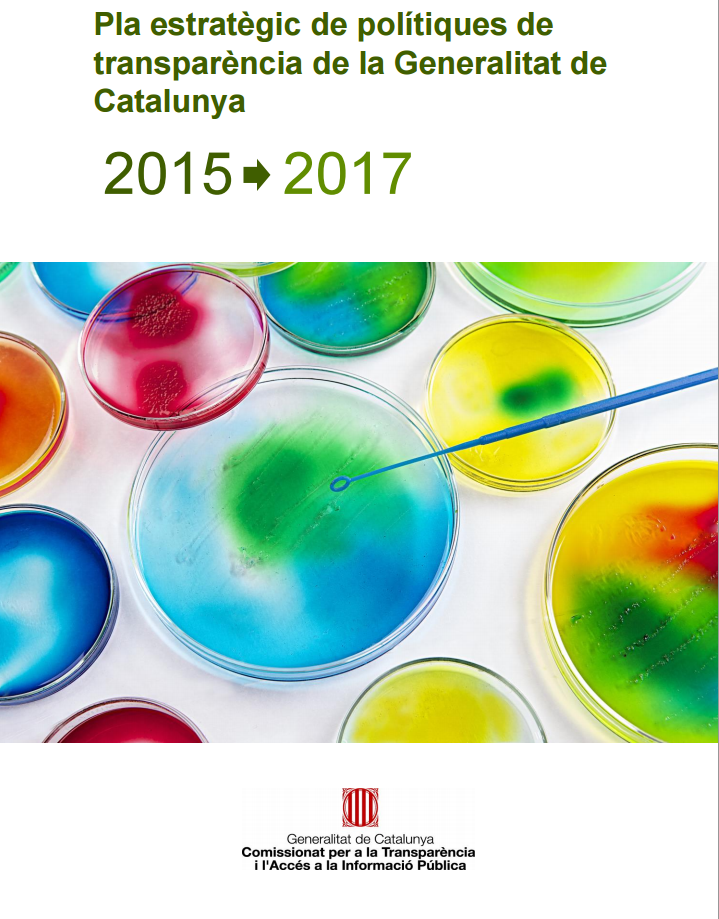

El Govern ha aprovat el Pla estratègic en polítiques de transparència 2015-2017, que estableix els objectius prioritaris del Govern en matèria de transparència de l’activitat pública, dret d’accés a la informació i documentació públiques, obligacions de bon govern i foment de la participació ciutadana i mesures de govern obert.
El Govern ha aprovat el Pla estratègic en polítiques de transparència 2015-2017, que estableix els objectius prioritaris del Govern en matèria de transparència de l’activitat pública, dret d’accés a la informació i documentació públiques, obligacions de bon govern i foment de la participació ciutadana i mesures de govern obert.
El document, previst per la Llei 19/2014 de transparència, accés a la informació pública i bon govern, que va entrar en vigor l’1 de juliol d’enguany, ha estat coordinat pel Comissionat per a la Transparència i l’Accés a la Informació Pública i el Consorci AOC hi ha participat activament.
El Pla estratègic en polítiques de transparència 2015-2017 s’estructura en sis eixos de treball, que al seu torn es desglossen en 32 objectius específics materialitzats en 124 actuacions, entre les quals figura l’establiment d’un programa de suport a les entitats locals.
Programa de suport a les entitats locals
El Pla inclou accions com les següents, per donar suport a les entitats locals en el compliment de les obligacions de transparència:
- Elaboració i signatura d’un conveni marc de col·laboració entre la Generalitat i el món local
- Elaboració d’una guia jurídica sobre l’aplicació de la Llei 19/2014 als ens locals
- Definició d’un pla de suport econòmic i financer als ens locals en compliment de l’article 94.1 de la Llei 19/2014.
- Oferiment per part del Consorci AOC d’una solució d’espai de Transparència per als governs locals
- Creació d’un repositori comú de dades obertes de transparència
- Oferiment per part del Consorci AOC d’una solució de tràmits electrònics de les sol·licituds d’accés d’informació i propostes / suggeriments
- Suport jurídic
- Formació als ens locals
Per a més informació sobre el Pla, podeu consultar la nota de premsa de la Generalitat.